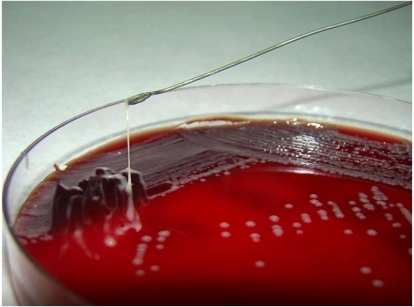

Klebsiella Endogenous Endophthalmitis and Eye Screening
The idea for this post arose from discussions and tutorials with local ID trainees, all (at least those I have contact with) of whom routinely send patients with community-acquired Klebsiella pneumoniae bacteraemia for eye screening by an ophthalmologist to “exclude endophthalmitis”, and some who apply the same practice even to patients with hospital-acquired Klebsiella pneumoniae bacteraemia.
Endogenous endophthalmitis occurs as a result of the “metastatic” spread of a pathogen from a distant site in the body to the eye via the bloodstream. It is far rarer than infectious exogenous endophthalmitis, where the pathogen is directly inoculated into the eye as a result of trauma, surgery or foreign bodies. The most commonly isolated pathogen in cases of endogenous endophthalmitis in Asia is Klebsiella pneumoniae, whereas Staphylococcus aureus and various streptococci predominant in western countries. In Singapore – although the data are old the results are probably not outdated – K. pneumoniae is isolated from approximately 60% of such cases (link is to a PubMed abstract as the actual article is behind the Elsevier pay wall).
It is important to note that not all K. pneumoniae strains are created equal, and only the hypervirulent (and hypermucoviscous) strains first described from Asia-Pacific countries in the 1980s are associated with endogenous endophthalmitis, whereas the “classical” strains that are common causes of hospital-acquired infections are not. How can one distinguish between a “hypervirulent” and a “classical” strain of K. pneumoniae? It is not quite straightforward to explain or determine without molecular tools (to detect the magA or rmpA genes, which are not present in “classical” strains, or to determine the serotype – with K1 and K2 being associated with the “hypervirulent” strain), but here is a short list of differentiating features:
- “Hypervirulent” strains are associated with “metastatic” foci of infection, particularly liver abscesses, in community-acquired infections in patients without hepatic disease or underlying hepatobiliary tract structural abnormalities (due to cancer or surgery).
- Unlike “classical” strains, “hypervirulent” strains are rarely associated with antimicrobial resistance. Although extended-spectrum beta-lactamase (ESBL)-producing serotype K1 K. pneumoniae have been reported causing community-acquired liver abscesses, the strains seem to be different from the typical “hypervirulent” strains on more in-depth molecular testing. In large series, approximately 0.9% of Klebsiella spp, community-acquired liver abscesses were caused by ESBL-producing isolates (actual paper behind a pay wall). The underlying reason for this “resistance” to acquiring antimicrobial resistance determinants is not known.
- In the microbiology laboratory, a positive string test (image below, reproduced from here) on K. pneumoniae colonies on solid agar media is suggestive that the isolate in question is a “hypervirulent” strain.
Endogenous endophthalmitis is present in approximately 3% to 11% of all invasive infections caused by “hypervirulent” K. pneumoniae. In Singapore, the figure is 3.8%, based on a study performed between 2004-2005 in patients admitted to Changi General Hospital by researchers from the Singapore National Eye Centre (SNEC). It is a devastating and rapidly progressive disease, with a dismal prognosis (with regards to recovery of visual acuity) despite aggressive therapy. The experience at different centres in Singapore, South Korea, and USA among other countries concur on this point. The global experience indicates that the affected patients are virtually always symptomatic (unless unable to verbalise symptoms, i.e. obtunded or confused from sepsis), and published experience from Singapore (behind the BMJ pay wall) suggests that endophthalmitis may occur up to one week after the onset of sepsis and up to 2 days after starting appropriate systemic antimicrobial therapy.
Back to the original question then: is there a point to performing routine eye screening for patients with K. pneumoniae invasive infections and, if so, how should these patients be screened? Here, we can perhaps be guided by the WHO (or Wilson and Jungner) classic criteria for screening tests.
- If one was careful enough to only select cases of “hypervirulent” K. pneumoniae invasive infections for screening, then one would have to screen between 10-30 cases to find one case of endogenous endophthalmitis. If one included all cases of K. pneumoniae bacteraemia (including those caused by the drug-resistant and/or hospital-acquired “classical” strains), then this number rises exponentially.
- The cost of an ophthalmologist performing the eye screen is not trivial – but perhaps small relative to the overall cost of hospitalisation for treatment of the Klebsiella sepsis. The ophthalmologist would have to review the patient on at least two separate days however, given that endopthalmitis may still develop two days after the initiation of appropriate systemic antibiotics.
- Would there be a difference in terms of outcomes? A later SNEC paper suggests that there could be, based on better eye outcomes after initiating routine eye screening for all K. pneumoniae community-acquired bacteraemia cases from the year 2000. It is not clear from a close reading of the paper that this claim can be substantiated, however, and the difference in outcomes might also have been due to better management of such patients over time – a common bias.
My own personal take on the question of eye screening for Klebsiella endogenous endophthalmitis is therefore quite a conservative one. Virtually all patients who ultimately develop this condition also develop symptoms quickly. I also have a unique anecdote: during my training years, like most of my other colleagues, I would send patients with Klebsiella liver abscess or community bacteraemia for eye screening. Once, I had a patient – an elderly man – with K. pneumoniae bacteraemia and liver abscess diagnosed within a couple of days of hospitalisation. I promptly send him to the ophthalmologist, who “cleared” him of endophthalmitis. The very next morning, he woke up complaining of eye pain and visual blurring, and an urgent ophthalmology review showed frank endophthalmitis. This was on the third day of intravenous ceftriaxone – the antibiotic considered standard treatment for these Klebsiella infections. Aggressive therapy including vitrectomy failed to save his eye. Therefore, I believe that:
- Patients with community-acquired K. pneumoniae liver abscess/bacteraemia and who are lucid are better served by educating them to report any visual symptoms – which should be followed up with an urgent ophthalmology consult should these develop – rather than blanket routine eye screening.
- Patients who are unable to report symptoms for various reasons should have their eyes examined daily until after 3 days of appropriate systemic antibiotic therapy.
- Sending patients with ESBL-positive K. pneumoniae bacteraemia or other invasive infection for routine eye screening can be considered a waste of time, money and healthcare resources until the epidemiology or antibiotic resistance profiles of the “hypervirulent” strains changes.
It would be interesting to learn of other perspectives on this matter.
[…] this is almost invariably Klebsiella pneumoniae liver abscess. This is the same type of Klebsiella pneumoniae that can cause endophthalmitis as described previously (one can also find some nice pictures and a short microbiological description […]
LikeLike
[…] had previously stated that unlike “classical” strains, “hypervirulent” strains of K. pneumoniae are r…, and this is also largely true here. However, there are isolates within the large collection that […]
LikeLike